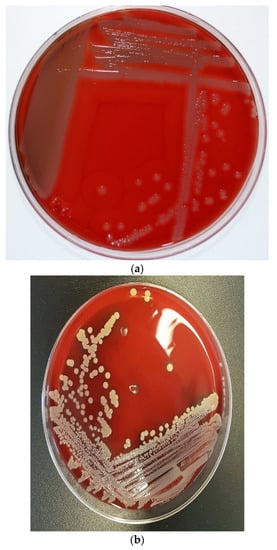
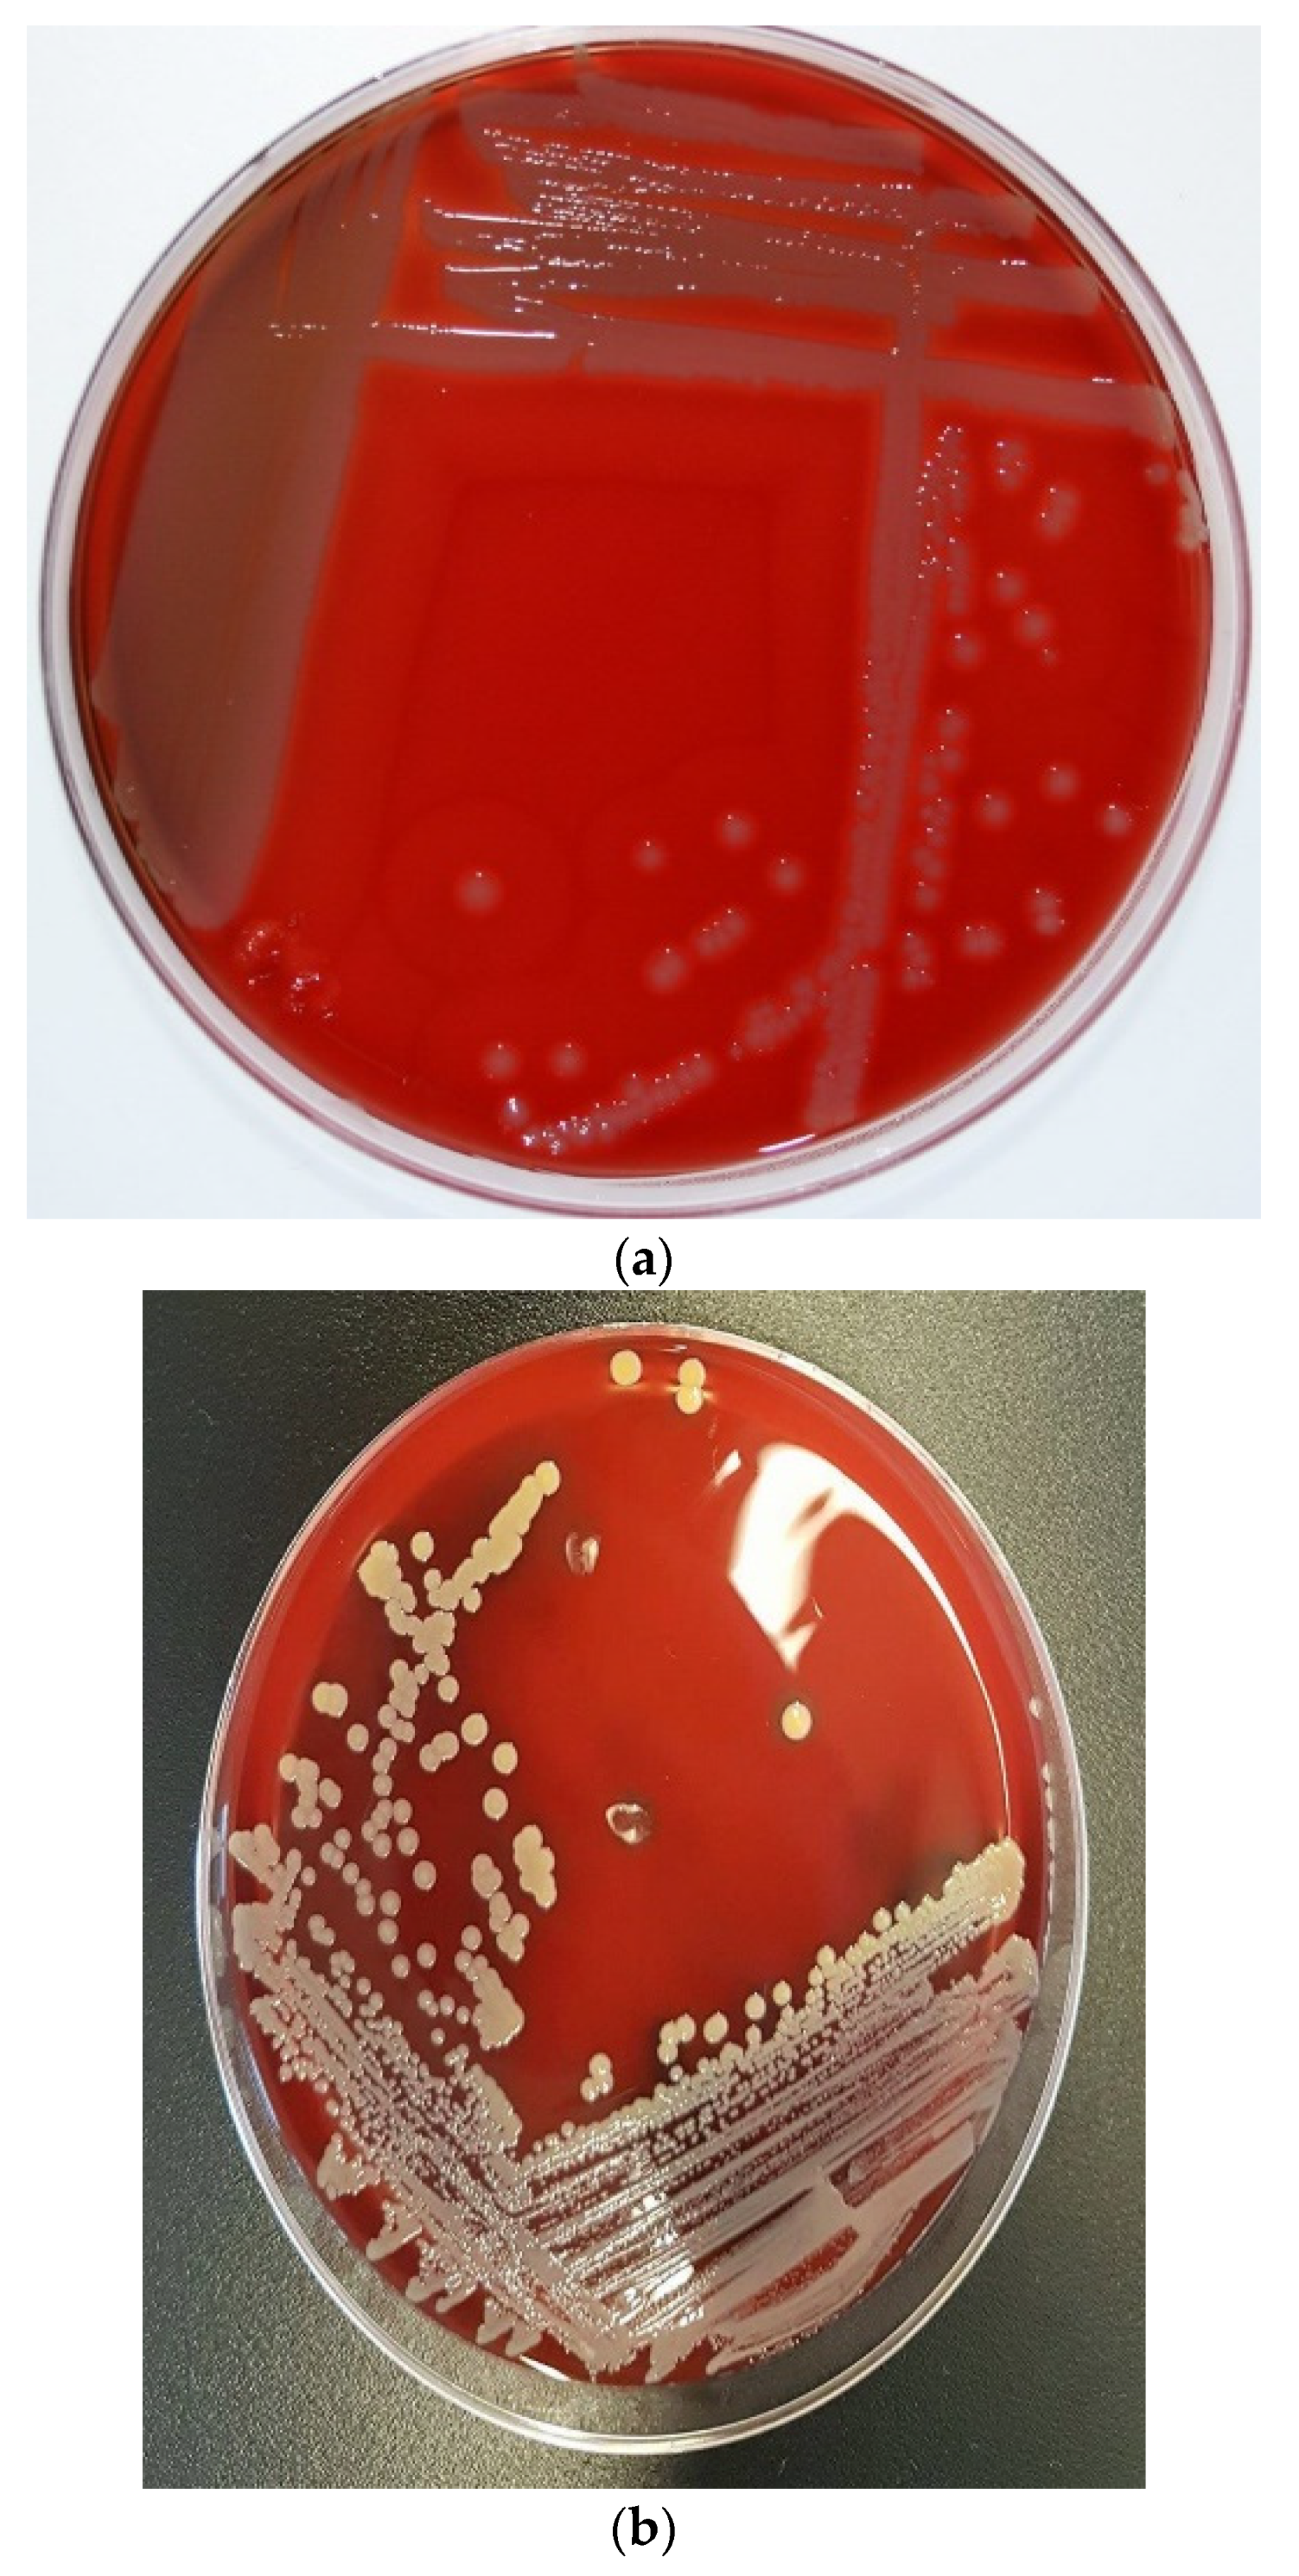
Microorganisms 11 00581 g001a
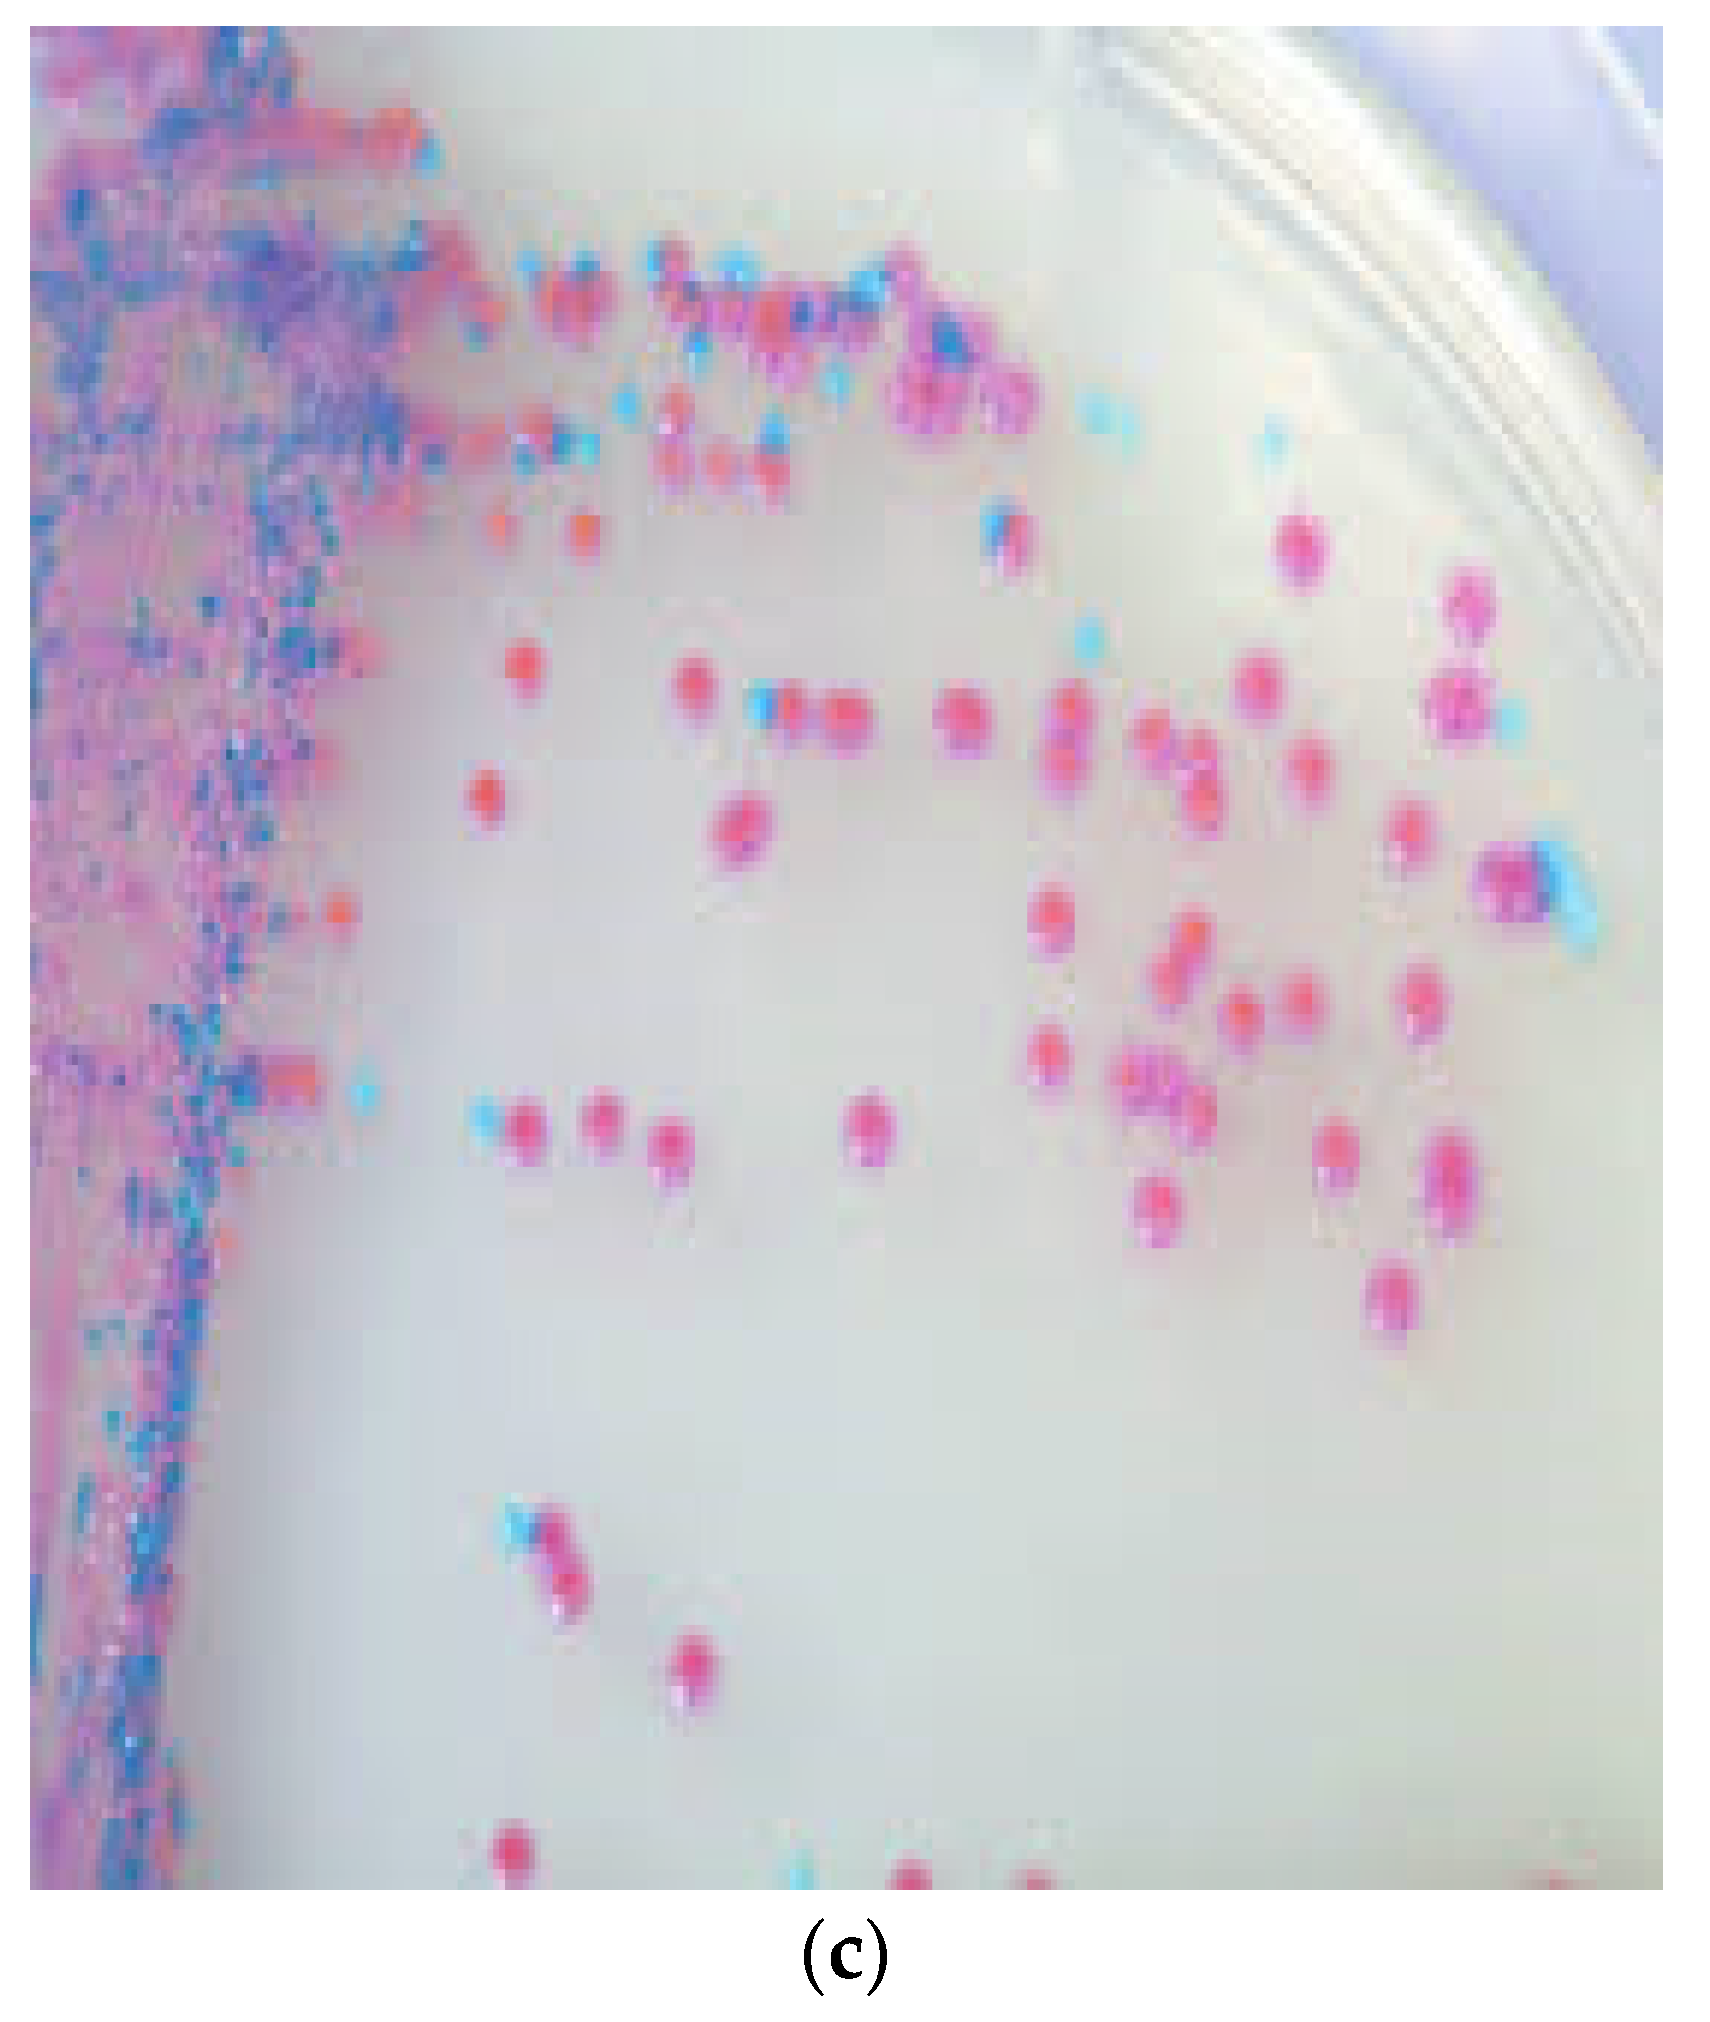
Microorganisms 11 00581 g001b

Abstract
S. pseudintermedius is a known resident of the skin and mucous membranes and a constituent of the normal microbiota of dogs. It has also been recognized as an opportunistic and zoonotic pathogen that is able to colonize humans and cause severe diseases, especially in immunocompromised hosts. Most importantly, methicillin-resistant S. pseudintermedius (MRSP), which is intrinsically multidrug-resistant, has emerged with serious public health consequences. The epidemiological situation is further exacerbated with reports of its zoonotic transmission and human infections which have been mostly attributed to the increasing frequency of dog ownership and close contact between dogs and humans. Evidence on the zoonotic transmission of MRSP from pet dogs to humans (such as dog owners, small-animal veterinarians, and other people in close proximity to dogs) is limited, especially due to the misidentification of S. pseudintermedius as S. aureus. Despite this fact, reports on the increasing emergence and spread of MRSP in humans have been increasing steadily over the years since its first documented report in 2006 in Belgium. The emergence of MRSP strains has further compromised treatment outcomes in both veterinary and human medicine as these strains are resistant to beta-lactam antimicrobials usually prescribed as first line treatment. Frustratingly, the limited awareness and surveillance of the zoonotic transmission of S. pseudintermedius have underestimated their extent of transmission, prevalence, epidemiology, and public health significance. In order to fill this gap of information, this review focused on detailed reports on zoonotic transmission, human colonization, and infections by S. pseudintermedius, their pathogenic features, antimicrobial resistance profiles, epidemiology, risk factors, and treatment. In writing this review, we searched Web of Science, PubMed, and SCOPUS databases using the keyword “Staphylococcus pseudintermedius AND humans”. A phylogenetic tree to determine the genetic relatedness/diversity of publicly available genomes of S. pseudintermedius was also constructed.
1. Introduction
Although, nasal carriage of Staphylococcus intermedius (almost certainly S. pseudintermedius prior to its reassignment) was reported among humans who had contacts with dogs [1], Staphylococcus pseudintermedius was first described as a novel species of the Staphylococcus intermedius group (SIG) in 2005 [2]. Three other coagulase-positive staphylococci, S. delphini, S. intermedius, S. cornubiensis, and one coagulase-negative strain, S. ursi, also form members of the SIG [3]. S. pseudintermedius, and especially multidrug-resistant (MDR) strains, have been recognized to be causative agents of skin infections such as canine pyoderma and surgical wound infections, especially in dogs [4,5,6]. S. pseudintermedius has also been isolated in cats and horses [4] but is not as ubiquitous as reported in dogs, where up to 77–90% of healthy dogs are colonized [5,7]. Besides being a normal commensal of dogs, S. pseudintermedius is also known for its challenging opportunistic potential, especially in immunocompromised hosts. In addition, S. pseudintermedius has been implicated in various cases of human colonization and infections, mostly due to close contact between companion dogs and humans [8,9,10,11,12,13]. S. pseudintermedius started gaining attention in recent years with the emergence of methicillin-resistant S. pseudintermedius (MRSP), which is intrinsically resistant to beta-lactam derivatives and other non-beta-lactam antimicrobials. Considerable publications on antibiotic-resistant S. pseudintermedius mostly focus on isolates recovered from dogs, while few reports on human MRSP exist in the literature [14]. S. pseudintermedius colonization is very similar to S. aureus colonization in humans, with the human nares being the most common source of colonization in contrast to the pharynx and rectum in companion animals [5,6]. Moses et al. reported that the perineum of dogs was more colonized than their nares and mouth [8]. Even though substantial numbers of articles on S. pseudintermedius pathogenesis in companion animals have been published, its role in human infections is still largely understudied and underestimated. In most series of case reports, S. pseudintermedius has been reported to be associated with skin and soft tissue infections (SSTIs) and sometimes with invasive infections in humans (especially in immunocompromised dog owners) [6]. S. pseudintermedius has emerged as a very important zoonotic pathogen due to the similarities of its pathogenic arsenals when compared to that of S. aureus [7]. The zoonotic transmission of S. pseudintermedius, including the multidrug-resistant traits (such as MRSP) from companion animals to human guardians or other people in close and constant contacts with their pets, is still largely under-recognized and highlights a significant gap in understanding its epidemiology and pathogenesis in humans. S. pseudintermedius has also been reported as a common etiologic agent of urinary tract infections and a common cause of opportunistic infections when the host normal defenses are compromised [15,16]. The first report of S. pseudintermedius infection in a human was a case of cardiac device pocket infection in 2006 when it was initially misidentified as S. aureus [17]. Series of case reports which initially reported S. intermedius and S. aureus infections in humans have also been reclassified as S. pseudintermedius with the aid of more sophisticated identification techniques, especially matrix-assisted laser/desorption ionization–time-of-flight mass spectrometry (MALDI-TOF MS), species-specific PCR (nuc gene targeting), multilocus sequence typing (MLST), and whole-genome sequencing (WGS). This has further encouraged the reporting of S. pseudintermedius in human infections with a possibility of understanding its pathogenic potentials, epidemiology, and adaptations and estimating its prevalence in humans. Based on series of available new evidence, S. pseudintermedius has been recognized as one of the three most clinically important pathogens in the EU by the European Food Safety Authority [18]. Although the development and application of advanced microbiological technologies have really helped in the emerging literature on human S. pseudintermedius epidemiology, a lot remains to be studied. In this review, we highlighted detailed reports on the evidence of S. pseudintermedius colonization and transmission to humans and its pathogenic potentials and treatment, adaptations, risk factors, and epidemiology.
We downloaded articles by searching PubMed, Web of Science, and SCOPUS databases using the keyword “Staphylococcus pseudintermedius AND humans” in writing this review. Our search was from the year 2006, when S. pseudintermedius was first reported in a human, to 1st of December 2022. Our search strategy focused only on publications that reported S. pseudintermedius colonization/infection in humans. In our literature search, we excluded other publications that reported only animal colonization/infection by S. pseudintermedius. We also excluded articles that reported S. intermedius. This search resulted in the retrieval of 106 publications, out of which 97 publications on human colonization/infection by S. pseudintermedius and its zoonotic transmission were selected after the exclusion of duplicated articles, non-pertinent publications, and other publications that reported S. intermedius. We also evaluated the genetic relationship of S. pseudintermedius by constructing a phylogenetic tree on the Bacterial and Viral Bioinformatics Resource Center (BV-BRC) platform, using the codon tree method. The alignment of 100 single-copy coding genes was performed by applying the maximum-likelihood (RAxML) algorithm. Among 582 public genomes of S. pseudintermedius, a total of 147 were selected to construct a phylogenetic tree by using the following filters: “host common name”, “MLST”, and “genome quality = good”. Reference genomes, S. pseudintermedius SP_11304_3A and S. aureus NCTC 8325, were also included as a representative strain or outgroup, respectively. The GenBank accession numbers and the additional metadata are shown in Supplementary Table S1.
2. Identification of S. pseudintermedius at the Species Level
Classical culture-based techniques have been the mainstay of clinical microbiology in previous centuries before the introduction of automated identification systems. The introduction of the API test kits and its automated versions (such as VITEK systems) influenced some level of success in microbial pathogen identification [19]. However, the database of these automated systems is well-populated by bacterial species commonly reported in human microbiology and have less representation of some emerging zoonotic pathogens, such as S. pseudintermedius. This negatively affected the identification of S. pseudintermedius since it is biochemically and phenotypically difficult to differentiate from other staphylococci (e.g., S. intermedius) [5,6,8]. In some automated systems, S. pseudintermedius is usually misidentified as S. aureus [4]. This has contributed greatly to the underestimation of the actual prevalence of S. pseudintermedius in both veterinary and human medicine. In some automated systems, S. pseudintermedius is usually misidentified as S. aureus [3]; however, there has been good improvement in the accurate identification of S. pseudintermedius as most automated systems are now updated with new software. S. pseudintermedius grows as small blue colonies on CHROMagar Staph aureusTM and as small, creamy grey-to-white, round 1–3 mm colonies with β-haemolysis on Columbia sheep blood agar [20]. The morphological appearances of S. pseudintermedius and its differentiation from S. aureus are shown in Figure 1. They are Gram-positive cocci in bunches with positive catalase test, typical of other staphylococci [20]. In addition, S. pseudintermedius is tube coagulase-positive but may be misidentified as coagulase-negative with the slide coagulase and commercial latex agglutination tests due to its slow and poor response [5,21]. The similarities in morphological and biochemical test results of S. pseudintermedius and S. aureus have led to series of misdiagnosis in human diagnostic laboratories, especially in most low- and middle-income countries without the financial capability to afford highly advanced identification machinery/techniques. However, despite this economic challenge, the morphology on agar plates and some biochemical tests such as acetoin production, hyaluronidase tests, mannitol fermentation, pyrrolidonyl arylamidase, polymyxin B susceptibility, beta-galactosidase production, and carbohydrate fermentation tests such as mannitol, maltose, and trehalose have proven to be useful in identifying and differentiating S. pseudintermedius from S. aureus [5,20,22] (Table 1). The introduction of new advanced technologies such as MALDI-TOF MS, PCR amplification of species-specific target genes such as the thermonuclease (nuc) gene [23], which differentiates S. pseudintermedius from S. aureus, and other SIG group members, and DNA sequencing techniques (such as multilocus sequence typing and whole-genome sequencing) in recent years has strongly helped in overcoming the disadvantages of the classical biochemical identification techniques. Multilocus sequence typing (MLST) is an important DNA sequencing technique for determining the epidemiological identities of pathogens [24]. In 2007, the first MLST scheme designed to evaluate the population genetic structure of the Staphylococcus intermedius group (SIG), which includes S. pseudintermedius, S. intermedius, and S, delphini, was based on 5 gene loci [25]. This scheme detected two major MRSP sequence types (STs): ST71 in Europe and ST68 in North America [6]. In 2013, Solyman et al. [26] launched the first species-specific MLST scheme, which is publicly available in a database (http://pubmlst.org/spseudintermedius/, accessed on 1 December 2022). As of December 2022, a total of 582 S. pseudintermedius genomes (mostly from dog) have been deposited on the MLST database. Whole-genome sequencing using an Oxford Nanopore MinION device and illumina sequencing platforms have proven to be very valuable in deciphering the complete genetic properties, epidemiological identities, and pathogenic potentials of S. pseudintermedius [4,6,7,25,26].
Figure 1.
Colony morphology of S. pseudintermedius and its differentiation from S. aureus. (a) Creamy grey-to-white colonies of S. pseudintermedius on Columbia sheep blood agar. (b) S. aureus growth on Columbia sheep blood agar. (c) Mixed culture of Staphylococci on CHROMagar Staph aureusTM (Oxoid, UK). Tiny blue colonies are S. pseudintermedius, while pink to mauve colonies are S. aureus.
Table 1.
Phenotypic Identification of S. pseudintermedius and its differentiation from S. aureus.
3. S. pseudintermedius Resistance to Beta-Lactams and Emergence of MRSP
In the last decade, the antimicrobial resistance patterns of S. pseudintermedius isolated from humans have not been well studied due to the inability of phenotypic and automated methods to properly identify and differentiate the pathogen from other human pathogens, such as S. aureus [27]. It is therefore particularly challenging and difficult to make definite and comprehensive statements on the resistance patterns of human S. pseudintermedius. However, despite these challenges, the emergence of antibiotic-resistant S. pseudintermedius with great relevance to human medicine has been noted from previous reports. Over the years, S. pseudintermedius has been observed to be frequently resistant to penicillinase-susceptible penicillins such as amoxicillin, ampicillin, and penicillin G. Of note, MRSP are considered to be resistant to beta-lactams according to the Clinical Laboratory Standards Institute (CLSI) and European Committee on Antimicrobial Susceptibility Testing (EUCAST) recommendations based on series of evaluated reports [14,28]. Oxacillin has been reported to be a better predictor of MRSP when compared to cefoxitin, which is mostly used for the accurate prediction of methicillin resistance in S. aureus and other coagulase-negative staphylococci [14,27,28]. To properly identify MRSP isolates, Wu et al. [28] carried out a study which evaluated cefoxitin and oxacillin disks, together with their MIC results, using 115 SIG isolated from veterinary and human clinical samples. They reported that oxacillin was a better predictor of MRSP isolates as it more accurately detected mecA resistance genes compared with cefoxitin [28]. Due to this and other series of reports, specific oxacillin breakpoints for MRSP detection with high reliability for mecA detection is oxacillin MIC of ≥0.5 mg/L (broth and agar dilution) and an inhibition zone diameter (IZD) of ≤17 mm (disc diffusion) according to the CLSI recommendations for isolates from both humans and animals [29]. In contrast to CLSI, EUCAST only defined an IZD of < 20 mm for MRSP detection without an available MIC breakpoint for agar and broth dilution [30]. The immunochromatographic detection of an altered penicillin-binding protein (PBP2a) of MRSP in contrast to its serological detection has also proven to be reliable in identifying methicillin resistance [6]. However, with recent advancement in molecular techniques, and also for high reliability of results, the phenotypically identified methicillin-resistant isolates must have a mecA gene to be genetically classified as MRSP [31]. Increasing emergence of MRSP in companion animals, especially among dogs and cats, has been discussed in other publications and reviews [32]; however, its emergence in human medicine, including its alarming rates of occurrence have not been properly addressed. The resistance of MRSP isolates to penicillinase-stable penicillins and oxacillin has attracted more attention in both veterinary and human medicine. In previous microarray studies in North America and Europe, 99% (102/103) MRSP isolates were identified to possess the blaZ gene which codes for a narrow-spectrum beta-lactamase [7,33]. Besides harboring the blaZ gene, MRSP are also known to possess the staphylococci cassette chromosome mec (SCCmec) gene, a mobile genetic element which harbors the mecA gene that codes for an alternative binding protein, PBP2a. In addition, arrays of SCCmec elements have been observed among different genetic lineages of MRSP, thereby suggesting that mecA genes might have been acquired multiple times by different S. pseudintermedius [4,32]. The transfer and exchange of SCCmec elements among different staphylococcal species is of significant public health concern as the staphylococci strains could evolve into superbugs causing “difficult-to-treat” infections. Series of reports tracing the origin of MRSP-specific SCCmec elements suggest that they might have been derived from or associated with S. aureus as well as other coagulase-positive staphylococci strains [34,35]. In humans, MRSP is rarely reported; however, the transfer potential of SCCmec elements and other resistance genes from MRSP to other staphylococcal species such as S. aureus has been hypothesized and is likely possible. It has been reported that the type of SCCmec elements present in MRSP seem to differ from those harbored by MRSA from genome sequencing results [36,37]. The SCCmec II-III hybrid, which is made up parts of previously identified SCCmec types II and III of MRSA, has been reported in S. pseudintermedius [36,38]. A total of 72.8% (75/103) MRSP isolates recovered from canines in North America, Europe, and Asia were reported to harbor the SCCmec II–III hybrid, while the remaining isolates harbored either SCCmec types III, IV, V, VII, or were not typeable [39]. Interestingly, most MRSP isolates recovered from human infections usually harbor the SCCmec III gene. A case of an implanted port catheter system infection caused by MRSP ST71-SCCmec III in a dog owner patient with hepatocellular carcinoma was reported in Japan [38]. This MRSP ST71-SCCmec III strain is a well-known epidemiological clone mostly isolated from dogs in Asia. MRSP harboring the SCCmec II–III genes have also been reported in various human infections, especially among people in close contact with dogs [14,40,41,42]. MRSP isolates carrying SCCmecV genes have also been reported in human infections [43,44] but in low frequency when compared to SCCmec II–III hybrid. MRSP has been recognized as an important pathogen in veterinary medicine with similar propensity in comparison to the healthcare-associated methicillin-resistant S. aureus (MRSA) in human medicine [39,45]. In Europe, the first case of MRSP was published in 2007 [46]. Since then, the occurrence of MRSP has been increasing steadily in both veterinary and, more recently, human medicine as it has been fingered as the cause of most wound infections and device-associated case reports, especially among dog owners or individuals in close contact with infected dogs. MRSP clones reported in North America (ST68), Europe (ST71), and Asia (ST45) have been observed to exhibit MDR to oral and most parental antimicrobials approved for veterinary use [4], thus creating a new and increasing pressure to use antimicrobials reserved for human medicine. This is worrying and calls for more surveillance programs to properly monitor the zoonotic transmission and pathogenesis of MRSP in humans.
4. Virulence Factors of S. pseudintermedius
S. pseudintermedius is equipped with a variety of virulence factors such as enterotoxins, coagulase, protease, haemolysin, siet exfoliative toxin, and seccanine enterotoxin, which empowers it to overcome the immune system arsenals and further increase the severity of infections in the infected host [20,21]. Of great interest is the possession of a leukotoxin virulence gene known as luk by S. pseudintermedius, which is similar to the Panton–Valentine leucocidin (PVL) found in S. aureus [20,22]. The SpsQ and protein A found in S. pseudintermedius are analogous to those found in S. aureus [47,48]. SpsD and spsL surface proteins, which facilitate adherence to human fibronectin, fibrinogen, and cytokeratin, have also been reported [49]. Some putative virulence features involved at various pathogenic stages of S. pseudintermedius infections (adhesion, immune evasion, and spread) have been described [50]. Most of the S. pseudintermedius virulence factors are similar to the ones described in S. aureus, thus explaining the similarity in severity of infections caused by both bacterial pathogens.
Implications of S. pseudintermedius Virulence Factors in Human Health
S. pseudintermedius infections in humans have been reported, but the roles of their virulence factors in human infections is largely understudied and therefore underestimated. Although human S. pseudintermedius infections are scarce because of reported low carriage frequency when compared to S. aureus, interestingly, an in vitro study showed that S. pseudintermedius expressed similar pathogenic potentials to S. aureus towards human cells [51].
Low S. pseudintermedius carriage frequencies even among high-risk groups such as pet guardians/owners and small-animal veterinarians, including other people in close contact with pets, have been reported in some studies. This might not be a definitive representation of the actual prevalence frequencies because misdiagnosis of S. aureus could be an important limiting factor underestimating its prevalence in humans. For example, a study in Sweden reported that 13 out of 101 isolates previously identified as S. aureus from human samples of infected dog-bite wounds were in fact found to be S. pseudintermedius after using molecular techniques. In addition, the isolates were found to harbor LukF/S-I, siet, se-int, expA, expB, and Seccanine genes [22]. A similar study that investigated the zoonotic transmission of S. pseudintermedius between dogs and dog guardians in different households revealed that three dog guardians (4.5%) were colonized by S. pseudintermedius [52]. Gomez-Sanz et al. [52] also observed that one of the S. pseudintermedius colonizing a dog guardian was similar to the one isolated from the corresponding dog. Interestingly, two S. pseudintermedius strains isolated from the dog guardians harbored the expA gene (an exfoliative toxin gene), further confirming the hypothesis that companion animal ownership is a significant risk factor for the zoonotic transmission of pathogenic S. pseudintermedius, including the MDR and MRSP strains. LukF/S-I and siet genes have also been reported in MRSP causing wound infections in a cluster of four cases in a tertiary hospital [42]. The possible animal source of the infections could not be identified as a follow-up sampling of the patients’ pets was not done. S. pseudintermedius harboring siet exfoliative genes and LukF/S-I genes were also isolated from a dog and its guardian suffering from severe skin infection [53]. S. pseudintermedius has also been reported to adhere to human fibronectin with greater internalization ability, intracellular persistence, and cytotoxicity using human osteoblasts than S. aureus [54]. A biofilm-producing antibiotic-resistant S. pseudntermedius strain was isolated from the wound of a human patient with chronic lymphoblastic leukaemia who had close contact with a companion dog [55]. In addition, the biofilm produced by the S. pseudintermedius pathogen was resistant to many antibiotics, including the last-line antimicrobials such as linezolid, tigecycline, and vancomycin. In another study, S. pseudintermedius strains isolated from humans were reported to harbor sea, seb, sec, see, and tst1 virulence genes [56]. The real significance of findings reporting the zoonotic transmission of S. pseudintermedius with their virulence factors from companion animals to their human guardians is difficult to evaluate because of the low number of isolates included in most of these studies.
5. The Zoonotic Transmission, Colonization/Infections, and Epidemiology of S. pseudintermedius in Humans
The close contact between companion animals (especially dogs and cats), their human guardians/owners, and other people such as small-animal veterinarians increases the likelihood of S. pseudintermedius (a normal commensal of dogs) adaptation in humans, as already mentioned. Veterinarians (3.9%, 5/128) have been reported to be colonized by MRSP [14]. A cohort study reported that human patients with a median age of 61 and older may be at higher risk of being infected by S. pseudintermedius from their dogs. Phumthanakorn and Prapasarakul [57] performed assays to determine the adherence ability of five MRSP isolates belonging to different sequence types (ST45, ST433, and ST733) from different sources on human corneocytes and reported that three isolates of MRSP ST45, the major clone in Thailand, had the strongest ability to adhere to human corneocytes among all the tested STs. This further highlights the epidemiological success of ST45 in Asia when compared to ST71, a previously successful clone in Europe. Interestingly, both ST45 and ST71 have disseminated globally, with ST71 being the most reported in human infections globally. In another study, Latronico et al. [58] compared the in vitro adherence potentials of four MRSP strains belonging to ST71, two non-ST71 strains, and three genetically unrelated MSSP on human corneocytes. They observed that MRSP ST71 strains showed greater adherence than MRSP non-ST71 and MSSP. This further proves the epidemiological success of human colonization by MRSP ST71 and its increasing global dissemination in series of case reports, especially among immunocompromised individuals who have contacts with dogs.
As noted earlier in this review, studies describing the zoonotic transmission, colonization, and infection of humans by S. pseudintermedius are few due to its misidentification as S. aureus and also due to the inability of most diagnostic laboratories to afford the use of newer technologies such as MALDI-TOF MS, species-specific gene targeting by PCR, MLST, and whole-genome sequencing, especially in developing countries. As a result of this, it is somewhat challenging to estimate its actual frequency of zoonotic transmission, human colonization and infection, and its current epidemiology. However, despite these challenges, we were able to give detailed information on most reports of zoonotic transmission, human colonization and infection, and the epidemiology of S. pseudintermedius in humans from 2006 when S. pseudintermedius was first reported in a human infection to 1 December 2022 [4,6,9,10,11,12,13,14,15,16,17,20,22,38,40,41,42,43,44,52,53,55,59,60,61,62,63,64,65,66,67,68,69,70,71,72,73,74,75,76,77,78,79,80,81,82,83]. A summary of all reported human S. pseudintermedius infections, zoonotic transmission, and colonization from 2006–1st of December 2022 is shown in Table 2. Most of the literature on human infections due to S. pseudintermedius cited case reports due to skin and soft tissue infections (SSTIs), device-associated, and invasive infections, especially among hospitalized patients who have or had prior contact with companion animals. In a case series, 12.9% (13/101) of S. pseudintermedius isolates previously identified as S. aureus were associated with dog-bite wounds of patients. In one of the largest case series involving 24 patients (18 SSTIs, 1 prosthetic joint infection, 1 skin infection, 1 lung infection, 1 bloodstream infection, 2 invasive infections–a monomicrobial prosthetic joint infection, and a fistula-associated bloodstream infection), S. pseudintermedius was identified as a significant component of a polymicrobial infection in 91.7% of the observed cases [6]. This study reported that 95.4% of the observed patients were dog owners and had close contact with their dogs before the S. pseudintermedius infections. Most of the infections reported in this case series were mild to moderate, so patients were primarily treated with oral antibiotics and managed as outpatients [6].
Table 2.
Summary of reports on S. pseudintermedius colonization and infections in humans from 2006–2022.
MRSP is known to originate from dog reservoir in contrast to MRSA strains whose main reservoir is human. MRSP is the primary staphylococcal species responsible for a plethora of dog infections [4]; however, its zoonotic transmission to humans is of public health significance even though S. aureus is currently a greater concern in human medicine. One (7.7%) MRSP isolate was reported among 13 S. pseudintermedius isolates recovered from dog bite wound infections in a case series [22]. Somayaji et al. [6] also isolated MRSP isolates which belonged to sequence types (ST71 and ST181) mostly reported in Europe in 3 patients [6,84]. ST71 and ST181 have been noted to also possess multidrug resistant traits, but so far, no MRSP resistance to vancomycin, daptomycin, or linezolid has been reported in isolates from humans. MRSP ST71 and ST 68 have been reported to be predominant in Europe and North America, respectively [7]. Previously, the MRSP Sequence Type 71 carrying the SCCmec III (MRSP ST71-SCCmec III) was regarded as an epidemic European clone usually isolated from dogs, but today, it is highly disseminated worldwide and recognized to be the major MRSP clone infecting humans in close contact with dogs, especially among the immunocompromised such as individuals with open wounds and medical devices [6,9,38,40,42]. Other S. pseudintermedius STs such as ST45, ST241, ST1337, ST1412, ST155, ST673, ST686, ST181, ST158, and ST233 have also been reported in human colonization and infections [22,41,44,64,70,73,81,85]. A study reported 5.6% S. pseudintermedius carriage rate among dog owners in a household [52,86]. Within households, S. pseudintermedius may also be transmitted through the fecal-oral routes due to the tendency of S. pseudintermedius to colonize the rectum and pharynx of dogs [5]. The zoonotic transmission of S. pseudintermedius in nosocomial settings may also occur [42].
6. Evolutionary Relationships of S. pseudintermedius Isolated from Humans and Animals: An Assessment of Their Genetic Relatedness/Diversity
To understand the genomic relationship among S. pseudintermedius isolated from humans and animals, a phylogenetic tree was built using the genomes deposited in the public database from 1999 to 2019. Publicly available genomes of S. pseudintermedius isolated from humans are few when compared to the ones from companion animals. To date, only 356 out of the publicly available 582 S. pseudintermedius genomes have their host information associated with them on the database. Most of the S. pseudintermedius strains were recovered from dogs (n = 328), followed by humans (n = 17), horses (5), cats (4), cows (n = 1), and seals (n = 1).
Herein, a total of 147 representative genomes of S. pseudintermedius isolated worldwide were selected to create the phylogeny of this species, using the following filters: “host common name”, “MLST”, and “genome quality = good”. Based on our analysis, the strains isolated from humans (MAD-487, -478, -479, -480, -486) and dogs (MRSP-586, -473, -476, VTH-775, MAD-404) in the USA in different years were closely related (Figure 2). A similar relationship was observed between strains AP20 and AI14 isolated from a human and a dog in Thailand, respectively (Figure 2 and Figure 3). In addition, strains MI-143131, -12-1817, and -07-1650 isolated from horses and MAD-401 and 063228 isolated from dogs were also genetically related (Figure 2). These results indicated a likely zoonotic and anthropozoonotic transmission of these S. pseudintermedius strains between humans and animals in the studied regions. The phylogenetic tree also showed that some of the related clones were recovered from different countries and different hosts, such as the strain CCUG-49543 from a cat in Sri Lanka and MAD-672 from a dog in the USA; VB88 from a human in Argentina and ST452 from a dog in Australia; thus, suggesting a close ancestry between them (Figure 2 and Figure 3).
Figure 2.
Strains of 147 S. pseudintermedius isolated from humans and animals worldwide. Reference genomes, S. pseudintermedius SP_11304_3A and S. aureus NCTC 8325, were also included. The color of the strain’s name represents the hosts, the color of the nodes indicates the country of isolation, and the node shape indicates the year of isolation. Estimated confidence is shown on each internal branch of the tree. * is just a form of emphasis on Node shape based on years. It was not used to represent the collection year type.
Figure 3.
World map showing countries with S. pseudintermedius reports, their MLSTs, and hosts. The information included in the map was based on selected criteria of the phylogenetic tree. Countries with S. pseudintermedius reports are shown in blue.
: human,
: horse,
: cat, and
: dog.
: human,
: horse,
: cat, and
: dog.
Based on the publicly deposited genomes, the most frequent ST observed among the strains was ST45 (n = 22), followed by ST71 (n = 21), ST496 (n = 16), ST258 (12), ST64 (n = 10), and ST68 (n = 6) being the least (Supplementary Table S1). The other STs observed had four or fewer representative strains (Supplementary Table S1). Interestingly, the closest clones recovered from the same country share identical STs, such as MRSP-473, -586, -476, MAD-404, -478, -480, -487, -479, -486, and VTH775 belonging to the ST71; MAD401, 063228, MI-12-1817, -07-1650, and -14-3131 belonging to ST68; and AP20 and AI14 belonging to ST181. Additionally, the strains recovered from different countries such as VB88 and ST452 belonged to the same ST (45). Although the publicly available genomes of S. pseudintermedius do not completely give an actual representation of the circulating STs, results of the phylogenetic tree analysis of the public genomes showed a worldwide epidemiological dissemination of ST45 and ST71 as the most dominant S. pseudintermedius STs in animals (especially dogs) and humans. This further highlights their lack of host specificity and the possibility of interspecies transmission.
7. Factors Associated with Acquisition of MRSP
Although the primary variables contributing to the rising frequency of MRSP have not yet been definitively discovered through studies, various potential risk factors have been noticed throughout time [87,88]. Of note, veterinary clinics and hospitals play important roles in the spread and zoonotic transmission of MRSP. Even though there are low numbers of reports on colonization, MRSP is even gradually being recognized as an occupational risk for veterinarians [14,40,41,52,62,86,89,90,91]. A carriage rate of 4% was reported among small-animal dermatologists [14]. Over the years, there has been an interesting significant increase in the number of case reports on MRSP infections in humans who have close contact with dogs [9,63,92]. Risk populations and recognized factors associated with the spread and transmission of MRSP infections include dog owners from MRSP-positive households [93], veterinarians [94], exposure to medical hospitals and environments, extensive wounds [93,94], underlying diseases, severity of illness, advanced age, gastrointestinal surgery, transplantation, prolonged hospitalization [94], exposure to invasive devices of all types (especially central venous catheters), immunosuppression [94,95], and antimicrobial administration to a dog or an owner [4,95,96,97]. It has been reported that people with very close contact with infected animals have a higher risk of being MRSP-positive [4]. This further supports that MRSP could be a more common bacterial pathogen in humans than previously estimated [22].
8. Antimicrobial Choices for the Treatment MRSP Infections and Its Challenges
The emergence of MRSP presents a new challenging public health problem to both veterinary and human medicine because therapeutics options are limited [82]. Due to the unpredictability of MRSP susceptibility to antimicrobials (especially non-beta-lactams), it is imperative to always conduct antimicrobial susceptibility testing in the treatment of MRSP infections in order to choose the best and most effective antimicrobial which will help to curtail the increasing spread of these zoonotic pathogens. Interestingly, aminoglycosides, tetracyclines, chloramphenicol, and rifampicins (also known as rifampins in some countries) are antibiotics to consider in the treatment of MRSP infections if antimicrobial susceptibility results indicate good activity. In contrast to the community-acquired MRSA in human medicine, MRSP originating from veterinary and human medicine have been noted to usually exhibit resistance to non-beta-lactam drugs such as trimethoprim–sulfamethoxazole, fluoroquinolones, lincosamides, macrolides, and tetracyclines [7,31,82].
9. Conclusions
Staphylococcus pseudintermedius is a well-recognized veterinary pathogen, mostly colonizing and causing diseases in dogs. However, in the last decade, pet (especially dog and cat) ownership in modern society has significantly increased [98]. This bacterial species could be transmitted from dogs to humans (especially dog owners and small-animal veterinarians) because of their frequent close contact. In fact, human colonization and infections due to S. pseudintermedius have been increasingly reported.
Nevertheless, to properly understand the prevalence, pathogenesis, and epidemiology of S. pseudintermedius in human medicine, it is important to precisely identify all the CoPS that are frequently misdiagnosed as S. aureus in human clinical samples. In routine microbiological diagnosis, phenotypic test results could be combined with host information to better distinguish these Staphylococcus bacteria.
Of special interest is the emergence of MRSP, which is usually intrinsically resistant to beta-lactam derivatives and exhibits multidrug resistance traits to other non-beta-lactam antimicrobials such as the sulfonamides, fluoroquinolones, lincosamides, macrolides, and tetracyclines. The emergence of MRSP represents a loss of antimicrobial effectiveness and further complicates the treatment of MRSP infections in both veterinary and human medicine. Furthermore, global epidemiological reports indicated that most MRSP strains infecting humans belong to ST45 (CC45), a dominant clone in Asia, and ST71 (CC71), a major epidemic clone found in dogs and also a previously known dominant clone in Europe, thus further reiterating its global epidemiological success. Finally, this review revealed that S. pseudintermedius strains should be evaluated from a One Health perspective, considering the close contact between humans and companion animals, and their consequent colonization/infection which will draw back the gains of One Health.
10. Future Outlook
The outlook to properly track and understand the zoonotic transmission of S. pseudintermedius will be for healthcare providers or physicians to consider asking patients infected with staphylococci routine questions on “contacts with animals”. Inadequate, incomplete, or lack of appropriate diagnosis is an important factor that has exacerbated the increasing antimicrobial resistance menace in both veterinary and human medicine due to antimicrobial misuse or abuse. The development, implementation, and application of advanced microbiology technologies with high discriminatory power and high efficiency have helped in the proper identification of S. pseudintermedius with a progressing opportunity in understanding and evaluating its pathogenesis, prevalence, epidemiology, and zoonotic transmission potentials. In the interim, the development or identification of important phenotypic tests which differentiate S. pseudintermedius from other members of staphylococci will be valuable in contributing to the correct estimation of S. pseudintermedius prevalence, especially for smaller diagnostic laboratories that cannot afford highly sophisticated identification techniques/machinery. The development of an ATLAS picture album, which would contain a series of morphological images of S. pseudintermedius and its differentiation from CoPS on different commercial or self-formulated culture media, will be very useful in screening for suspected S. pseudintermedius colonies before identification confirmation. Further prospective and longitudinal studies on human S. pseudintermedius will be very valuable to properly decipher and understand the transmission, risk factors, pathogenic potentials, and epidemiology of this opportunistic and zoonotic pathogen.
Supplementary Materials
The following supporting information can be downloaded at: https://www.mdpi.com/article/10.3390/microorganisms11030581/s1.
Author Contributions
Conceptualization, A.C.G.; methodology, A.C.G., I.B.M. and F.F.S.; literature review, A.C.G., I.B.M. and F.F.S.; writing—original draft: A.C.G., I.B.M. and F.F.S.; writing—review: all authors; supervision, A.C.G.; funding acquisition, A.C.G. All authors have read and agreed to the published version of the manuscript.
Funding
I.B. Moses received a Young Talent Fellowship grant (Fellowship Number: 88887.580642/2020-00) supported by Coordenacao de Aperfeicoamento de Pessoal de Nivel Superior-Brasil (CAPES). A.C. Gales was partially funded by National Council for Science and Technological Development (CNPq), Brazil (Process number: 312066/2019-8).
Institutional Review Board Statement
Not applicable.
Informed Consent Statement
Not applicable.
Data Availability Statement
Not applicable.
Conflicts of Interest
A. C. Gales has recently received research funding and/or consultation fees from bioMerieux Eurofarma, MSD, Pfizer, Roche, Sandoz, União Química, and United Medical. The other authors have nothing to declare.
References
- Harvey, R.G.; Marples, R.R.; Noble, W.C. Nasal Carriage of Staphylococcus intermedius in Humans in Contact with Dogs. Microb. Ecol. Health Dis. 1994, 7, 225–227. [Google Scholar]
- Devriese, L.A.; Vancanneyt, M.; Baele, M.; Vaneechoutte, M.; De Graef, E.; Snauwaert, C.; Cleenwerck, I.; Dawyndt, P.; Swings, J.; Decostere, A.; et al. Staphylococcus pseudintermedius sp. nov., a coagulase-positive species from animals. Int. J. Syst. Evol. Microbiol. 2005, 55 Pt 4, 1569–1573. [Google Scholar] [CrossRef]
- Carroll, K.C.; Burnham, C.D.; Westblade, L.F. From canines to humans: Clinical importance of Staphylococcus pseudintermedius. PLoS Pathog. 2021, 17, e1009961. [Google Scholar] [CrossRef]
- van Duijkeren, E.; Catry, B.; Greko, C.; Moreno, M.A.; Pomba, M.C.; Pyorala, S.; Ruzauskas, M.; Sanders, P.; Threlfall, E.J.; Torren-Edo, J.; et al. Review on methicillin-resistant Staphylococcus pseudintermedius. J. Antimicrob. Chemother. 2011, 66, 2705–2714. [Google Scholar] [CrossRef] [PubMed]
- Rubin, J.; Chirino-Trejo, M. Prevalence, sites of colonization, and antimicrobial resistance among Staphylococcus pseudintermedius isolates from healthy dogs in Saskatoon, Canada. J. Vet. Diagn. Investig. 2011, 23, 351–354. [Google Scholar] [CrossRef]
- Somayaji, R.; Madalagama, R.; Rubin, J. Human infections due to Staphylococcus pseudintermedius, an emerging zoonoses of canine origin: A report of 24 cases. Diagn. Microb. Infect. Dis. 2016, 85, 471–476. [Google Scholar] [CrossRef]
- Perreten, V.; Kadlec, K.; Schwarz, S. Clonal spread of methicillin-resistant Staphylococcus pseudintermedius in Europe and North America: An international multicentre study. J. Antimicrob. Chemother. 2010, 65, 1145–1154. [Google Scholar] [CrossRef]
- Moses, I.B.; Esimone, C.O.; Iroha, I.R.; Ugbo, E.N.; Orji, J.O.; Nwuzo, A.C.; Nwakaeze, E.A.; Agumah, N.B.; Emioye, A.A.; Ukpai, E.G.; et al. First report on the antibiotic resistance profiles and virulence genes of Staphylococcus pseudintermedius colonizing dogs and humans in Abakaliki, South-East Nigeria. Res. J. Microbiol. 2020, 15, 22–34. [Google Scholar] [CrossRef]
- Stegmann, R.; Burnens, A.; Maranta, C.A.; Perreten, V. Human infection associated with methicillin-resistant Staphylococcus pseudintermedius ST71. J. Antimicrob. Chemother. 2010, 65, 2047–2048. [Google Scholar] [CrossRef]
- Chuang, C.Y.; Yang, Y.L.; Hsueh, P.R.; Lee, P.I. Catheter-related bacteremia caused by Staphylococcus pseudintermedius refractory to antibiotic lock therapy in a hemophilic child with dog exposure. J. Clin. Microbiol. 2010, 48, 1497–1498. [Google Scholar] [CrossRef]
- Blondeau, L.D.; Rubin, J.E.; Deneer, H.; Deutscher, M.; Kanthan, R.; Sanche, S.; Beshard, N.; Mpofu, C.; Blondeau, J.M. Bacteremia with Staphylococcus pseudintermedius in a 4-month-old pediatric oncology patient. J. Chemother. 2020, 32, 260–262. [Google Scholar] [CrossRef] [PubMed]
- Small, C.; Beatty, N.; El Helou, G. Staphylococcus pseudintermedius Bacteremia in a Lung Transplant Recipient Exposed to Domestic Pets. Cureus 2021, 7, e14895. [Google Scholar] [CrossRef]
- Asleh, M.; Feinstein, Y.; Lazar, I.; Rokney, A.; Baum, M.; Sagi, O.; Leibovitz, E.; Danino, D. Severe Pneumonia Caused by Methicillin-Resistant Staphylococcus pseudintermedius in an Oncology Patient: Case Report and Literature Review. Microb. Drug Resist. 2022, 28, 222–228. [Google Scholar] [CrossRef] [PubMed]
- Paul, N.C.; Moodley, A.; Ghibaudo, G.; Guardabassi, L. Carriage of methicillin-resistant Staphylococcus pseudintermedius in small animal veterinarians: Indirect evidence of zoonotic transmission. Zoonoses Public Health 2011, 58, 533–539. [Google Scholar] [CrossRef]
- Subedi, P.; Syed, M.P.; Kate, Y.; Koirala, B. Staphylococcus pseudintermedius: A common zoonotic pathogen causing postprocedural urosepsis in humans. BMJ Case Rep. 2021, 14, e238170. [Google Scholar] [CrossRef]
- Blondeau, L.D.; Deutscher, M.; Rubin, J.E.; Deneer, H.; Kanthan, R.; Sanche, S.; Blondeau, J.M. Urinary tract infection in a human male patient with Staphylococcus pseudintermedius transmission from the family dog. J. Chemother. 2022, 34, 133–136. [Google Scholar] [CrossRef] [PubMed]
- Van Hoovels, L.; Vankeerberghen, A.; Boel, A.; Van Vaerenbergh, K.; De Beenhouwer, H. First Case Staphylococcus Pseudintermedius Infect. A Hum. J. Clin. Microbiol. 2006, 44, 4609–4612. [Google Scholar] [CrossRef]
- EFSA AHAW Panel (EFSA Panel on Animal Health and Welfare); Nielsen, S.S.; Bicout, D.J.; Calistri, P.; Canali, E.; Drewe, J.A.; Garin-Bastuji, B.; Gonzales Rojas, J.L.; Gortazar Schmidt, C.; Herskin, M.; et al. Ad hoc method for the assessment of animal diseases caused by bacteria resistant to antimicrobials. EFSA J. 2021, 19, e06645. [Google Scholar]
- Guardabassi, L.; Damborg, P.; Stamm, I.; Kopp, P.A.; Broens, E.M.; Toutain, P.L.; ESCMID Study Group for Veterinary Microbiology. Diagnostic microbiology in veterinary dermatology: Present and future. Vet Dermatol. 2017, 28, 146-e30. [Google Scholar] [CrossRef]
- Moses, I.B.; Esimone, C.O.; Iroha, I.R.; Rubin, J.E.; Sniatynsky, M.K.; Ribeiro, A.C.S.; Santos, F.F.; Cayo, R.; Gales, A.C. Antibiotypes and high frequency of toxin genes in methicillin-resistant Staphylococcus pseudintermedius from nares of dogs and dog guardians in Nigeria. Comp. Immunol. Microbiol. Infect. Dis. 2022, 89, 101870. [Google Scholar] [CrossRef]
- Bannoehr, J.; Guardabassi, L. Staphylococcus pseudintermedius in the dog: Taxonomy, diagnostics, ecology, epidemiology and pathogenicity. Vet. Dermatol. 2012, 23, 253–266.e51-2. [Google Scholar] [CrossRef] [PubMed]
- Börjesson, S.; Gómez-Sanz, E.; Ekström, K.; Torres, C.; Grönlund, U. Staphylococcus pseudintermedius can be misdiagnosed as Staphylococcus aureus in humans with dog bite wounds. Eur. J. Clin. Microbiol. Infect. Dis. 2015, 34, 839–844. [Google Scholar] [CrossRef] [PubMed]
- Sasaki, T.; Tsubakishita, S.; Tanaka, Y.; Sakusabe, A.; Ohtsuka, M.; Hirotaki, S.; Kawakami, T.; Fukata, T.; Hiramatsu, K. Multiplex-PCR method for species identification of coagulase-positive staphylococci. J. Clin. Microbiol. 2010, 48, 765–769. [Google Scholar] [CrossRef] [PubMed]
- Spratt, B.G.; Maiden, M.C.J. Bacterial population genetics, evolution, and epidemiology. Philos. Trans. R. Soc. B Biol. Sci. 1999, 354, 701–710. [Google Scholar] [CrossRef]
- Bannoehr, J.; Ben Zakour, N.; Waller, A.; Guardabassi, L.; Thoday, K.; van den Broek, A.; Fitzgerald, J. Population genetic structure of the Staphylococcus intermedius group: Insights into agr diversification and the emergence of methicillin-resistant strains. J. Bacteriol. 2007, 189, 8685–8692. [Google Scholar] [CrossRef]
- Solyman, S.M.; Black, C.C.; Duim, B.; Perreten, V.; van Duijkeren, E.; Wagenaar, J.A.; Eberlein, L.C.; Sadeghi, L.N.; Videla, R.; Bemis, D.A.; et al. Multilocus sequence typing for characterization of Staphylococcus pseudintermedius. J. Clin. Microbiol. 2013, 51, 306–310. [Google Scholar] [CrossRef]
- Bhooshan, S.; Negi, V.; Khatri, P.K. Staphylococcus pseudintermedius: An undocumented, emerging pathogen in humans. GMS Hyg. Infect. Control 2020, 15, Doc32. [Google Scholar]
- Wu, M.T.; Burnham, C.A.; Westblade, L.F.; Dien Bard, J.; Lawhon, S.D.; Wallace, M.A.; Stanley, T.; Burd, E.; Hindler, J.; Humphries, R.M.; et al. Evaluation of oxacillin and cefoxitin disk and MIC breakpoints for prediction of methicillin resistance in human and veterinary isolates of Staphylococcus intermedius group. J. Clin. Microbiol. 2016, 54, 535–542. [Google Scholar] [CrossRef]
- CLSI. Performance Standards for Antimicrobial Susceptibility Testing, M100, 32nd ed.; Clinical and Laboratory Standards Institute: Wayne, PA, USA, 2022; Available online: https://clsi.org/ (accessed on 20 January 2023).
- EUCAST. Breakpoint Tables for Interpretation of MICs and Zone Diameters, Version 12.0. 2022. Available online: http://www.eucast.org (accessed on 20 January 2023).
- Bemis, D.A.; Jones, R.D.; Frank, L.A.; Kania, S.A. Evaluation of susceptibility test breakpoints used to predict mecA-mediated resistance in Staphylococcus pseudintermedius isolated from dogs. J. Vet. Diag. Investig. 2009, 21, 53–58. [Google Scholar] [CrossRef]
- Weese, J.S.; van Duijkeren, E. Methicillin-resistant Staphylococcus aureus and Staphylococcus pseudintermedius in veterinary medicine. Vet. Microbiol. 2010, 140, 418–429. [Google Scholar] [CrossRef]
- Kadlec, K.; Schwarz, S.; Perreten, V.; Andersson, U.G.; Finn, M.; Greko, C.; Moodley, A.; Kania, S.A.; Frank, L.A.; Bemis, D.A.; et al. Molecular analysis of methicillin-resistant Staphylococcus pseudintermedius of feline origin from different European countries and North America. J. Antimicrob. Chemother. 2010, 65, 1826–1828. [Google Scholar] [CrossRef]
- Descloux, S.; Rossano, A.; Perreten, V. Characterization of new staphylococcal cassette chromosome mec (SCCmec) and topoisomerase genes in fluoroquinolone and methicillin-resistant Staphylococcus pseudintermedius. J. Clin. Microbiol. 2008, 46, 1818–1823. [Google Scholar] [CrossRef] [PubMed]
- Perreten, V.; Chanchaithong, P.; Prapasarakul, N.; Rossano, A.; Blum, S.E.; Elad, D.; Schwendener, S. Novel pseudo SCCmec element (wSCCmec57395) in methicillin-resistant Staphylococcus pseudintermedius CC45. Antimicrob. Agents Chemother. 2013, 57, 5509–5515. [Google Scholar] [CrossRef] [PubMed]
- Rich, M.; Roberts, L. MRSA in companion animals. Vet Rec. 2006, 159, 535–536. [Google Scholar] [CrossRef] [PubMed]
- Weese, J.S.; Faires, M.; Rousseau, J.; Mathews, K.A. Cluster of methicillin-resistant Staphylococcus aureus colonization in a small animal intensive care unit. J. Am. Vet. Med. Assoc. 2007, 231, 1361–1364. [Google Scholar] [CrossRef] [PubMed]
- Kitagawa, H.; Hisatsune, J.; Ohge, H.; Kutsuno, S.; Hara, T.; Masuda, K.; Aziz, F.; Sugai, M. Implanted Port Catheter System Infection Caused by Methicillin-resistant Staphylococcus pseudintermedius ST71-SCCmec type III. Intern Med. 2021, 60, 2337–2340. [Google Scholar] [CrossRef]
- EMA/CVMP/SAGAM. Revised Reflection Paper on the Use of 3rd and 4th Generation Cephalosporins in Food Producing Animals in the European Union: Development of Resistance and Impact on Human and Animal Health. 2009. Available online: http://www.ema.europa.eu/docs/en_GB/document_library/Scientific_guideline/2009/10/WC500004307.pdf (accessed on 20 January 2023).
- Boost, M.V.; So, S.Y.; Perreten, V. Low rate of methicillin-resistant coagulase positive staphylococcal colonization of veterinary personnel in Hong Kong. Zoonoses Public Health 2011, 58, 36–40. [Google Scholar] [CrossRef]
- Chanchaithong, P.; Perreten, V.; Schwendener, S. Strain typing and antimicrobial susceptibility of methicillin-resistant coagulase-positive staphylococcal species in dogs and people associated with dogs in Thailand. J. Appl. Microbiol. 2014, 117, 572–586. [Google Scholar] [CrossRef]
- Starlander, G.; Borjesson, S.; Gronlund-Andersson, U. Cluster of infections caused by methicillin-resistant Staphylococcus pseudintermedius in humans in a tertiary hospital. J. Clin. Microbiol. 2014, 52, 3118–3120. [Google Scholar] [CrossRef]
- Frank, L.A.; Kania, S.A.; Kirzeder, E.; Eberlein, L.; Bemis, D. Risk of colonization or gene transfer to owners of dogs with methicillin-resistant Staphylococcus pseudintermedius. Vet. Dermatol. 2009, 20, 496–501. [Google Scholar] [CrossRef]
- Gagetti, P.; Wattam, A.R.; Giacoboni, G.; De Paulis, A.; Bertona, E.; Corso, A.; Rosato, A.E. Identification and molecular epidemiology of methicillin resistant Staphylococcus pseudintermedius strains isolated from canine clinical samples in Argentina. BMC Vet. Res. 2019, 15, 264. [Google Scholar] [CrossRef]
- Boag, A.K.; Loeffler, A.; Lloyd, D.H. Methicillin-resistant Staphylococcus aureus isolates from companion animals. Vet. Rec. 2004, 154, 411. [Google Scholar]
- British Small Animal Veterinary Association (BSAVA). BSAVA/SAMSoc Antibiotics Advice. 2007. Available online: http://www.bsava.com/ (accessed on 20 January 2023).
- Bannoehr, J.; Ben Zakour, N.L.; Reglinski, M.; Inglis, N.F.; Prabhakaran, S.; Fossum, E.; Smith, D.G.; Wilson, G.J.; Cartwright, R.A.; Haas, J.; et al. Genomic and surface proteomic analysis of the canine pathogen Staphylococcus pseudintermedius reveals proteins that mediate adherence to the extracellular matrix. Infect. Immun. 2011, 79, 3074–3086. [Google Scholar] [CrossRef]
- Balachandran, M.; Bemis, D.A.; Kania, S.A. Expression and function of protein a in Staphylococcus pseudintermedius. Virulence 2018, 9, 390–401. [Google Scholar] [CrossRef] [PubMed]
- Ben Zakour, N.L.; Beatson, S.A.; van den Broek, A.H.; Thoday, K.L.; Fitzgerald, J.R. Comparative genomics of the Staphylococcus intermedius group of animal pathogens. Front. Cell. Infect. Microbiol. 2012, 2, 44. [Google Scholar] [CrossRef] [PubMed]
- Hill, P.B.; Imai, A. The immunopathogenesis of staphylococcal skin infections—A review. Comp. Immunol. Microbiol. Infect. Dis. 2016, 49, 8–28. [Google Scholar] [CrossRef] [PubMed]
- Maali, Y.; Badiou, C.; Martins-Simoes, P.; Hodille, E.; Bes, M.; Vandenesch, F.; Lina, G.; Diot, A.; Laurent, F.; Trouillet-Assant, S. Understanding the Virulence of Staphylococcus pseudintermedius: A major role of pore-forming toxins. Front. Cell. Infect. Microbiol. 2018, 8, 221. [Google Scholar] [CrossRef]
- Gomez-Sanz, E.; Torres, C.; Ceballos, S. Clonal dynamics of nasal Staphylococcus aureus and Staphylococcus pseudintermedius in dog-owning household members. Detection of Methicillin Susceptible Staphylococcus aureus Strain. PLoS ONE 2013, 8, e69337. [Google Scholar] [CrossRef]
- Robb, A.R.; Wright, E.D.; Foster, A.M.E.; Walker, R.; Malone, C. Skin infection caused by a novel strain of Staphylococcus pseudintermedius in a Siberian husky dog owner. JMM Case Rep. 2017, 4. [Google Scholar] [CrossRef]
- Maali, Y.; Martins-Simoes, P.; Valour, F.; Bouvard, D.; Rasigade, J.P.; Bes, M.; Haenni, M.; Ferry, T.; Laurent, F.; Trouillet-Assant, S. Pathophysiological mechanisms of Staphylococcus non-aureus bone and joint infection: Interspecies homogeneity and specific behavior of S. pseudintermedius. Front. Microbiol. 2016, 7, 1063. [Google Scholar] [CrossRef]
- Pompilio, A.; De Nicola, S.; Crocetta, V.; Guarnieri, S.; Savini, V.; Carretto, E.; Di Bonaventura, G. New insights in Staphylococcus pseudintermedius pathogenicity: Antibiotic-resistant biofilm formation by a human wound-associated strain. BMC Microbiol. 2015, 15, 109. [Google Scholar] [CrossRef] [PubMed]
- Rahmdel, S.; Hosseinzadeh, S.; Shekarforoush, S.S.; Torriani, S.; Gatto, V.; Pashangeh, S. Safety hazards in bacteriocinogenic Staphylococcus strains isolated from goat and sheep milk. Microb. Pathog. 2018, 116, 100–108. [Google Scholar] [CrossRef]
- Phumthanakorn, N.; Prapasarakul, N. Investigating the ability of methicillin-resistant Staphylococcus pseudintermedius isolates from different sources to adhere to canine and human corneocytes. Can. J. Vet. Res. 2019, 83, 231–234. [Google Scholar]
- Latronico, F.; Moodley, A.; Nielsen, S.S.; Guardabassi, L. Enhanced adherence of methicillin-resistant Staphylococcus pseudintermedius sequence type 71 to canine and human corneocytes. Vet. Res. 2014, 45, 70. [Google Scholar] [CrossRef]
- Hanselman, B.; Kruth, S.; Rousseau, J.; Weese, J. Coagulase positive staphylococcal colonization of humans and their household pets. Can. Vet. J. 2009, 50, 954–958. [Google Scholar]
- Riegel, P.; Jesel-Morel, L.; Laventie, B.; Boisset, S.; Vandenesch, F.; Prévost, G. Coagulase-positive Staphylococcus pseudintermedius from animals causing human endocarditis. Int. J. Med. Microbiol. 2011, 301, 237–239. [Google Scholar] [CrossRef]
- Laarhoven, L.M.; de Heus, P.; van Luijn, J.; Duim, B.; Wagenaar, J.A.; van Duijkeren, E. Longitudinal study on methicillin-resistant Staphylococcus pseudintermedius in households. PLoS ONE 2011, 6, e27788. [Google Scholar] [CrossRef] [PubMed]
- Soedarmanto, I.; Kanbar, T.; Ülbegi-Mohyla, H.; Hijazin, M.; Alber, J.; Lämmler, C.; Akineden, Ö.; Weiss, R.; Moritz, A.; Zschöck, M. Genetic relatedness of methicillin-resistant Staphylococcus pseudintermedius (MRSP) isolated from a dog and the dog owner. Res. Vet. Sci. 2011, 91, e25–e27. [Google Scholar] [CrossRef] [PubMed]
- Savini, V.; Babarini, D.; Polakowska, K.; Gherardi, G.; Bialecka, A.; Kasprowicz, A. Methicillin-Resistant Staphylococcus pseudintermedius Infection in a Bone Marrow Transplant Recipient. J. Clin. Microbiol. 2013, 51, 1636–1638. [Google Scholar] [CrossRef]
- Youn, J.H.; Moodley, A.; Park, Y.H.; Sugimoto, C. Genome sequence of methicillin-resistant Staphylococcus pseudintermedius sequence type 233 (ST233) Strain K7 of human origin. Genome Announc. 2013, 1, e00310-13. [Google Scholar] [CrossRef]
- Lozano, C.; Marí, A.; Aspiroz, C.; Gómez-Sanz, E.; Ceballos, S.; Fortuño, B.; Barcenilla, F.; Jover-Sáenz, A.; Torres, C. Nasal carriage of coagulase positive staphylococci in patients of a Primary-Healthcare-Center: Genetic lineages and resistance and virulence genes. Enferm. Infecc. Microbiol. Clin. 2015, 33, 391–396. [Google Scholar] [CrossRef] [PubMed]
- Kuan, E.C.; Yoon, A.J.; Vijayan, T.; Humphries, R.M.; Suh, J.D. Canine Staphylococcus pseudintermedius sinonasal infection in human hosts. Int. Forum. Allergy Rhinol. 2016, 6, 710–715. [Google Scholar] [CrossRef]
- Darlow, C.A.; Paidakakos, N.; Sikander, M.; Atkins, B. A spinal infection with Staphylococcus pseudintermedius. BMJ Case Rep. 2017, 2017, bcr2017221260. [Google Scholar] [CrossRef] [PubMed]
- Lozano, C.; Rezusta, A.; Ferrer, I.; Pérez-Laguna, V.; Zarazaga, M.; Ruiz-Ripa, L.; Revillo, M.J.; Torres, C. Staphylococcus pseudintermedius Human Infection Cases in Spain: Dog-to-Human Transmission. Vector Borne Zoonotic Dis. 2017, 17, 268–270. [Google Scholar] [CrossRef] [PubMed]
- Kmieciak, W.; Szewczyk, E.M. Are zoonotic Staphylococcus pseudintermedius strains a growing threat for humans? Folia Microbiol. (Praha) 2018, 63, 743–747. [Google Scholar] [CrossRef] [PubMed]
- Phumthanakorn, N.; Fungwithaya, P.; Chanchaithong, P.; Prapasarakul, N. Enterotoxin gene profile of methicillin-resistant Staphylococcus pseudintermedius isolates from dogs, humans and the environment. J. Med. Microbiol. 2018, 67, 866–873. [Google Scholar] [CrossRef]
- Feßler, A.T.; Schuenemann, R.; Kadlec, K.; Hensel, V.; Brombach, J.; Murugaiyan, J.; Oechtering, G.; Burgener, I.A.; Schwarz, S. Methicillin-resistant Staphylococcus aureus (MRSA) and methicillin-resistant Staphylococcus pseudintermedius (MRSP) among employees and in the environment of a small animal hospital. Vet. Microbiol. 2018, 221, 153–158. [Google Scholar] [CrossRef]
- Rodrigues, A.C.; Belas, A.; Marques, C.; Cruz, L.; Gama, L.T.; Pomba, C. Risk Factors for Nasal Colonization by Methicillin-Resistant Staphylococci in Healthy Humans in Professional Daily Contact with Companion Animals in Portugal. Microbial. Drug Resist. 2018, 24, 434–446. [Google Scholar] [CrossRef]
- Kronbichler, A.; Blane, B.; Holmes, M.A.; Wagner, J.; Parkhill, J.; Peacock, S.J.; Jayne, D.R.W.; Harrison, E.M. Nasal carriage of Staphylococcus pseudintermedius in patients with granulomatosis with polyangiitis. Rheumatology 2019, 58, 548–550. [Google Scholar] [CrossRef]
- Dahbour, L.; Gibbs, J.; Coletta, C.; Hummell, J.; Al-Sarie, M.; Kahlon, N.P.; Akpunonu, B. Peritoneal Dialysis Zoonotic Bacterial Peritonitis with Staphylococcus pseudintermedius. Case Rep. Nephrol. Dial. 2020, 10, 65–70. [Google Scholar] [CrossRef]
- Nomoto, H.; Kutsuna, S.; Nakamura, K.; Nakamoto, T.; Shimomura, A.; Hirakawa, T.; Kinoshita, N.; Hayakawa, K.; Nagashima, M.; Ohmagari, N. Totally implantable venous access port infection caused by Staphylococcus pseudintermedius: Possible transmission from a companion dog to a human. J. Infect. Chemother. 2020, 26, 1305–1308. [Google Scholar] [CrossRef]
- Wegener, A.; Broens, E.M.; van der Graaf-van Bloois, L.; Zomer, A.L.; Visser, C.E.; van Zeijl, J.; van der Meer, C.; Kusters, J.G.; Friedrich, A.W.; Kampinga, G.A.; et al. Absence of Host-Specific Genes in Canine and Human Staphylococcus pseudintermedius as Inferred from Comparative Genomics. Antibiotics 2021, 10, 854. [Google Scholar] [CrossRef]
- Bowen, S.; DeMarco, A.; Villasis, L.; Barsi, J.; Handel, A.S. One Affectionate Puppy: A Case of Septic Arthritis Due to Staphylococcus pseudintermedius. Pediatr. Infect. Dis. J. 2021, 40, e381–e383. [Google Scholar] [CrossRef] [PubMed]
- Blondeau, L.D.; Sanche, S.; Sauder, D.J.; Deneer, H.; Kanthan, R.; Rubin, J.E.; Morrison, B.J.; Blondeau, J.M. Recovery of borderline oxacillin-resistant Staphylococcus pseudintermedius (BORSP) from bone and soft tissue of a rheumatoid arthritis patient with severe osteoporosis: Transmission from the family dog. J. Chemother. 2021, 33, 348–353. [Google Scholar] [CrossRef] [PubMed]
- Abusleme, F.; Galarce, N.; Quezada-Aguiluz, M.; Iragüen, D.; González-Rocha, G. Characterization and antimicrobial susceptibility of coagulase-positive Staphylococcus isolated in a veterinary teaching hospital in Chile. Rev. Argent. Microbiol. 2022, 54, 192–202. [Google Scholar] [CrossRef] [PubMed]
- Lai, C.H.; Ma, Y.C.; Shia, W.Y.; Hsieh, Y.L.; Wang, C.M. Risk Factors for Antimicrobial Resistance of Staphylococcus Species Isolated from Dogs with Superficial Pyoderma and Their Owners. Vet. Sci. 2022, 9, 306. [Google Scholar] [CrossRef] [PubMed]
- Wegener, A.; Duim, B.; van der Graaf-van Bloois, L.; Zomer, A.L.; Visser, C.E.; Spaninks, M.; Timmerman, A.J.; Wagenaar, J.A.; Broens, E.M. Within-Household Transmission and Bacterial Diversity of Staphylococcus pseudintermedius. Pathogens 2022, 11, 850. [Google Scholar] [CrossRef]
- Cuny, C.; Layer-Nicolaou, F.; Weber, R.; Köck, R.; Witte, W. Colonization of Dogs and Their Owners with Staphylococcus aureus and Staphylococcus pseudintermedius in Households, Veterinary Practices, and Healthcare Facilities. Microorganisms 2022, 10, 677. [Google Scholar] [CrossRef]
- Freites, C.O.; Hendrick, S.Y.; Miguez, P.; Salonia, J. Uncommon pathogens in an immunocompetent host: Respiratory isolation of Cunninghamella bertholletiae, Aspergillus niger, Staphylococcus pseudintermedius and adenovirus in a patient with necrotising pneumonia. BMJ Case Rep. CP 2022, 15, e240484. [Google Scholar] [CrossRef]
- Moodley, A.; Damborg, P.; Nielsen, S.S. Antimicrobial resistance in methicillin susceptible and methicillin-resistant Staphylococcus pseudintermedius of canine origin: Literature review from 1980 to 2013. Vet. Microbiol. 2014, 171, 337–341. [Google Scholar] [CrossRef]
- Robb, S.L.; Hanson-Abromeit, D.; May, L.; Hernandez-Ruiz, E.; Allison, M.; Beloat, A.; Daugherty, S.; Kurtz, R.; Ott, A.; Oyedele, O.O. Reporting quality of music intervention research in healthcare: A systematic review. Complement. Ther. Med. 2018, 38, 24–41. [Google Scholar] [CrossRef] [PubMed]
- Walther, B.; Hermes, J.; Cuny, C.; Wieler, L.H.; Vincze, S.; Abou Elnaga, Y.; Stamm, I.; Kopp, P.A.; Kohn, B.; Witte, W. Sharing more than friendship-nasal colonization with coagulase-positive staphylococci (CPS) and co-habitation aspects of dogs and their owners. PLoS ONE 2012, 7, e35197. [Google Scholar] [CrossRef]
- Radford, A.D.; Noble, P.J.; Coyne, K.P.; Jones, P.H.; Bryan, J.G.; Setzkorn, C.; Tierney, Á.; Dawson, S. Antibacterial prescribing patterns in small animal veterinary practice identified via SAVSNET: The small animal veterinary surveillance network. Vet. Rec. 2011, 169, 310. [Google Scholar] [CrossRef]
- Mateus, A.; Brodbelt, D.C.; Barber, N.; Stark, K.D.C. Antimicrobial usage in dogs and cats in first opinion veterinary practices in the UK. J. Small Anim. Pract. 2011, 52, 515–521. [Google Scholar] [CrossRef]
- Ishihara, K.; Shimokubo, N.; Sakagami, A.; Ueno, H.; Muramatsu, Y.; Kadosawa, T.; Yanagisawa, C.; Hanaki, H.; Nakajima, C.; Suzuki, Y.; et al. Occurrence and molecular characteristics of methicillin-resistant Staphylococcus aureus and methicillin-resistant Staphylococcus pseudintermedius in an academic veterinary hospital. Appl Environ. Microbiol. 2010, 76, 5165–5174. [Google Scholar] [CrossRef]
- Jordan, D.; Simon, J.; Fury, S.; Moss, S.; Giffard, P.; Maiwald, M.; Southwell, P.; Barton, M.D.; Axon, J.E.; Morris, S.G.; et al. Carriage of methicillin-resistant Staphylococcus aureus by veterinarians in Australia. Aust. Vet. J. 2011, 89, 152–159. [Google Scholar] [CrossRef] [PubMed]
- Sasaki, T.; Kikuchi, K.; Tanaka, Y.; Takahashi, N.; Kamata, S.; Hiramatsu, K. Methicillin-resistant Staphylococcus pseudintermedius in a veterinary teaching hospital. J. Clin. Microbiol. 2007, 45, 1118–1125. [Google Scholar] [CrossRef]
- Hatch, S.; Sree, A.; Tirrell, S.; Torres, B.; Rothman, A.L. Metastatic complications from Staphylococcus intermedius, a zoonotic pathogen. J. Clin. Microbiol. 2012, 50, 1099–1101. [Google Scholar] [CrossRef]
- Catry, B.; Van Duijkeren, E.; Pomba, M.C.; Greko, C.; Moreno, M.A.; Pyörälä, S.; Ruzauskas, M.; Sanders, P.; Threlfall, E.J.; Ungemach, F. Reflection paper on MRSA in food-producing and companion animals: Epidemiology and control options for human and animal health. Epidemiol. Infect. 2010, 138, 626–644. [Google Scholar] [CrossRef] [PubMed]
- Nienhoff, U.; Kadlec, K.; Chaberny, I.F.; Verspohl, J.; Gerlach, G.F.; Schwarz, S.; Simon, D.; Nolte, I. Transmission of methicillin resistant Staphylococcus aureus strains between humans and dogs: Two case reports. J. Antimicrob. Chemother. 2009, 64, 660–662. [Google Scholar] [CrossRef]
- Gronthal, T.; Moodley, A.; Nykasenoja, S. Large outbreak caused by methicillin resistant Staphylococcus pseudintermedius ST71 in a Finnish veterinary teaching hospital—From outbreak control to outbreak prevention. J. Clin. Microbiol. 2014, 9, 110–184. [Google Scholar] [CrossRef] [PubMed]
- Nienhoff, U.; Kadlec, K.; Chaberny, I.F.; Verspohl, J.; Gerlach, G.F.; Kreienbrock, L.; Schwarz, S.; Simon, D.; Nolte, I. Methicillin-resistant Staphylococcus pseudintermedius among dogs admitted to a small animal hospital. Vet. Microbiol. 2011, 150, 191–197. [Google Scholar] [CrossRef]
- Pomba, C.; Rantala, M.; Greko, C.; Baptiste, K.E.; Catry, B.; van Duijkeren, E.; Mateus, A.; Moreno, M.A.; Pyörälä, S.; Ružauskas, M.; et al. Public health risk of antimicrobial resistance transfer from companion animals. J. Antimicrob. Chemother. 2017, 72, 957–968. [Google Scholar] [CrossRef] [PubMed]
- Finisterra, L.; Duarte, B.; Peixe, L.; Novais, C.; Freitas, A.R. Industrial dog food is a vehicle of multidrug-resistant enterococci carrying virulence genes often linked to human infections. Int. J. Food Microbiol. 2021, 358, 109284. [Google Scholar] [CrossRef] [PubMed]
Disclaimer/Publisher’s Note: The statements, opinions and data contained in all publications are solely those of the individual author(s) and contributor(s) and not of MDPI and/or the editor(s). MDPI and/or the editor(s) disclaim responsibility for any injury to people or property resulting from any ideas, methods, instructions or products referred to in the content. |
© 2023 by the authors. Licensee MDPI, Basel, Switzerland. This article is an open access article distributed under the terms and conditions of the Creative Commons Attribution (CC BY) license (https://creativecommons.org/licenses/by/4.0/).